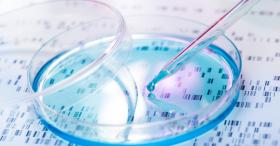

Navigating the Landscape of Rare Genetic Diseases: A Roadmap for Patients, Parents, and Providers
This conference is free of charge thanks to the support of the American Institute for Neuro Integrative Development (AIND), the Genesis Foundation for Children
THIS IS A VIRTUAL COURSE
You will receive the Zoom link upon registering.
More than 10,000 rare diseases are estimated to impact over 30 million Americans. Unfortunately, many individuals remain undiagnosed, leading to prolonged and challenging journeys in pursuit of understanding and proper care. These often place significant burdens on families and strain our medical system. Rapid advancements in genetics have significantly enhanced our diagnostic capabilities and care recommendations, with targeted therapies emerging for select disorders. However, navigating the complex landscape of evaluation and testing options for diagnosis remains a challenge for both families and medical professionals. This program is designed to provide patients, families, and healthcare providers (including both primary and specialty physicians) with the latest insights into a genetic evaluation. Featuring six expert MGH/HMS genetics providers and families of patients, the course covers clinically relevant fundamentals of human genetics, genetic counseling, and the latest technological advancements in diagnostics and therapies.Through engaging lectures and real-life patient perspectives, participants will enhance their understanding of the intricacies surrounding rare genetic disorders. Whether you are a family facing the challenges of diagnosis, a medical provider, or someone with a general interest in the field, this program aims to empower attendees with knowledge to advocate for those affected by these unique conditions.
Target Audience
This activity is intended for Physicians, Nurses, Nurse Practitioners, Dentists, Dieticians, Psychologists, Physician Assistants, and Social Workers across the country, as well as General Public, and Patients & Caregivers.
Learning Objectives
Upon completion of this activity, participants will be able to:
- Recognize the value as well as strengths, limitations, and pitfalls of genetic testing.
- Identify the common diagnostic genetic tests used and gain familiarity with test result interpretation.
- Recognize the value of multidisciplinary coordinated care for individuals with rare genetic syndromes.
- Recognize genetic disorders currently amenable to targeted therapies and new therapeutic possibilities on the horizon.
ABP MOC RECOGNITION STATEMENT
Successful completion of this CME activity, which includes participation in the evaluation component, enables the learner to earn up to 6 MOC points in the American Board of Pediatrics’ (ABP) Maintenance of Certification (MOC) program. It is the CME activity provider’s responsibility to submit learner completion information to ACCME for the purpose of granting ABP MOC credit.
ABIM MOC RECOGNITION STATEMENT
Successful completion of this CME activity, which includes participation in the activity, with individual assessments of the participant and feedback to the participant, enables the participant to earn 6 MOC points in the American Board of Internal Medicine (ABIM) Maintenance of Certification (MOC) program. It is the CME activity provider’s responsibility to submit participant completion information to ACCME for the purpose of granting ABIM MOC credit.
Additional Information
Massachusetts General Hospital and Mass General Brigham
| 8:00am | Welcome Remarks | David Sweetser, MD, PhD |
| 8:15 | Embarking on the journey: “Could there be a genetic cause?" | Catherine Nowak, MD |
| 9:00 | Complexities of interpreting genetic test results: “This test report is confusing, what does it mean?” | Ashley Wong, MS CGC |
| 9:45 | BREAK |
| 10:00 | Our test result indicates there may be a diagnosis. “Now what”? | Frances High, MD, PhD |
| 10:45 | At the end of the diagnostic odyssey: Seeking a home for coordinated care. "Where, Who, How?" | Angela Lin, MD |
| 11:30 | Parent Perspective Panel | Matthew Hoffman, Jessica Fieber, Zhanna Ullman |
| 12:30pm | LUNCH BREAK |
| 1:00 | What's on the horizon for diagnostic genetic testing? | David Sweetser, MD, PhD |
| 1:45 | What’s on the Horizon for Targeted Therapies? | Melissa Walker, MD PhD |
| 2:30 | Speaker Panel Discussion | David Sweetser, MD, PhD; Catherine Nowak, MD; Ashley Wong, MS CGC; Frances High, MD, PhD; Angela Lin, MD; Melissa Walker, MD PhD |
| 3:00pm | Farewell/Adjourn |
David Sweetser, MD, PhD - Course Director
Clinical Geneticist, Research Scientist,
Chief of Medical Genetics and Metabolism,
MGH Site Director Undiagnosed Diseases Network,
Co-Director Pitt Hopkins Clinic,
Massachusetts General Hospital
Frances High, MD, PhD
Clinical Geneticist, Research Scientist, Co-Director Klinefelter Syndrome Clinic,
Director of Reproductive Endocrinology and Infertility Genetics, Massachusetts General Hospital for Children
Angela Lin, MD
Clinical Geneticist, Co-Director Turner Syndrome and Myhre Syndrome Clinics,
Director Pediatric Hereditary Hemorrhagic Telangiectasia Center, MassGeneral for Children
Catherine Nowak, MD
Clinical Geneticist, Clinical Director, Division of Medical Genetics and Metabolism,
Massachusetts General Hospital for Children
Melissa Walker, MD, PhD
Neurologist, Research Scientist, Director Neuro-Pediatric Mitochondrial Disorders Clinic,
Massachusetts General Hospital for Children
Ashley Wong, MS, LCGC
Genetic Counselor, Massachusetts General Hospital for Children
Assistant Professor, MGH Institute of Health Professions
In support of improving patient care, Mass General Brigham is jointly accredited by the Accreditation Council for Continuing Medical Education (ACCME), the Accreditation Council for Pharmacy Education (ACPE), and the American Nurses Credentialing Center (ANCC), to provide continuing education for the healthcare team.
Credit Designation Statement
AMA PRA Category 1 Credits™
Mass General Brigham designates this live activity for a maximum of 6 AMA PRA Category 1 Credits™. Physicians should claim only the credit commensurate with the extent of their participation in the activity.
Available Credit
- 6.00 ABP Lifelong Learning and Self-Assessment
- 6.00 AMA PRA Category 1 Credit™
- 6.00 Participation

Facebook
X
LinkedIn
Forward